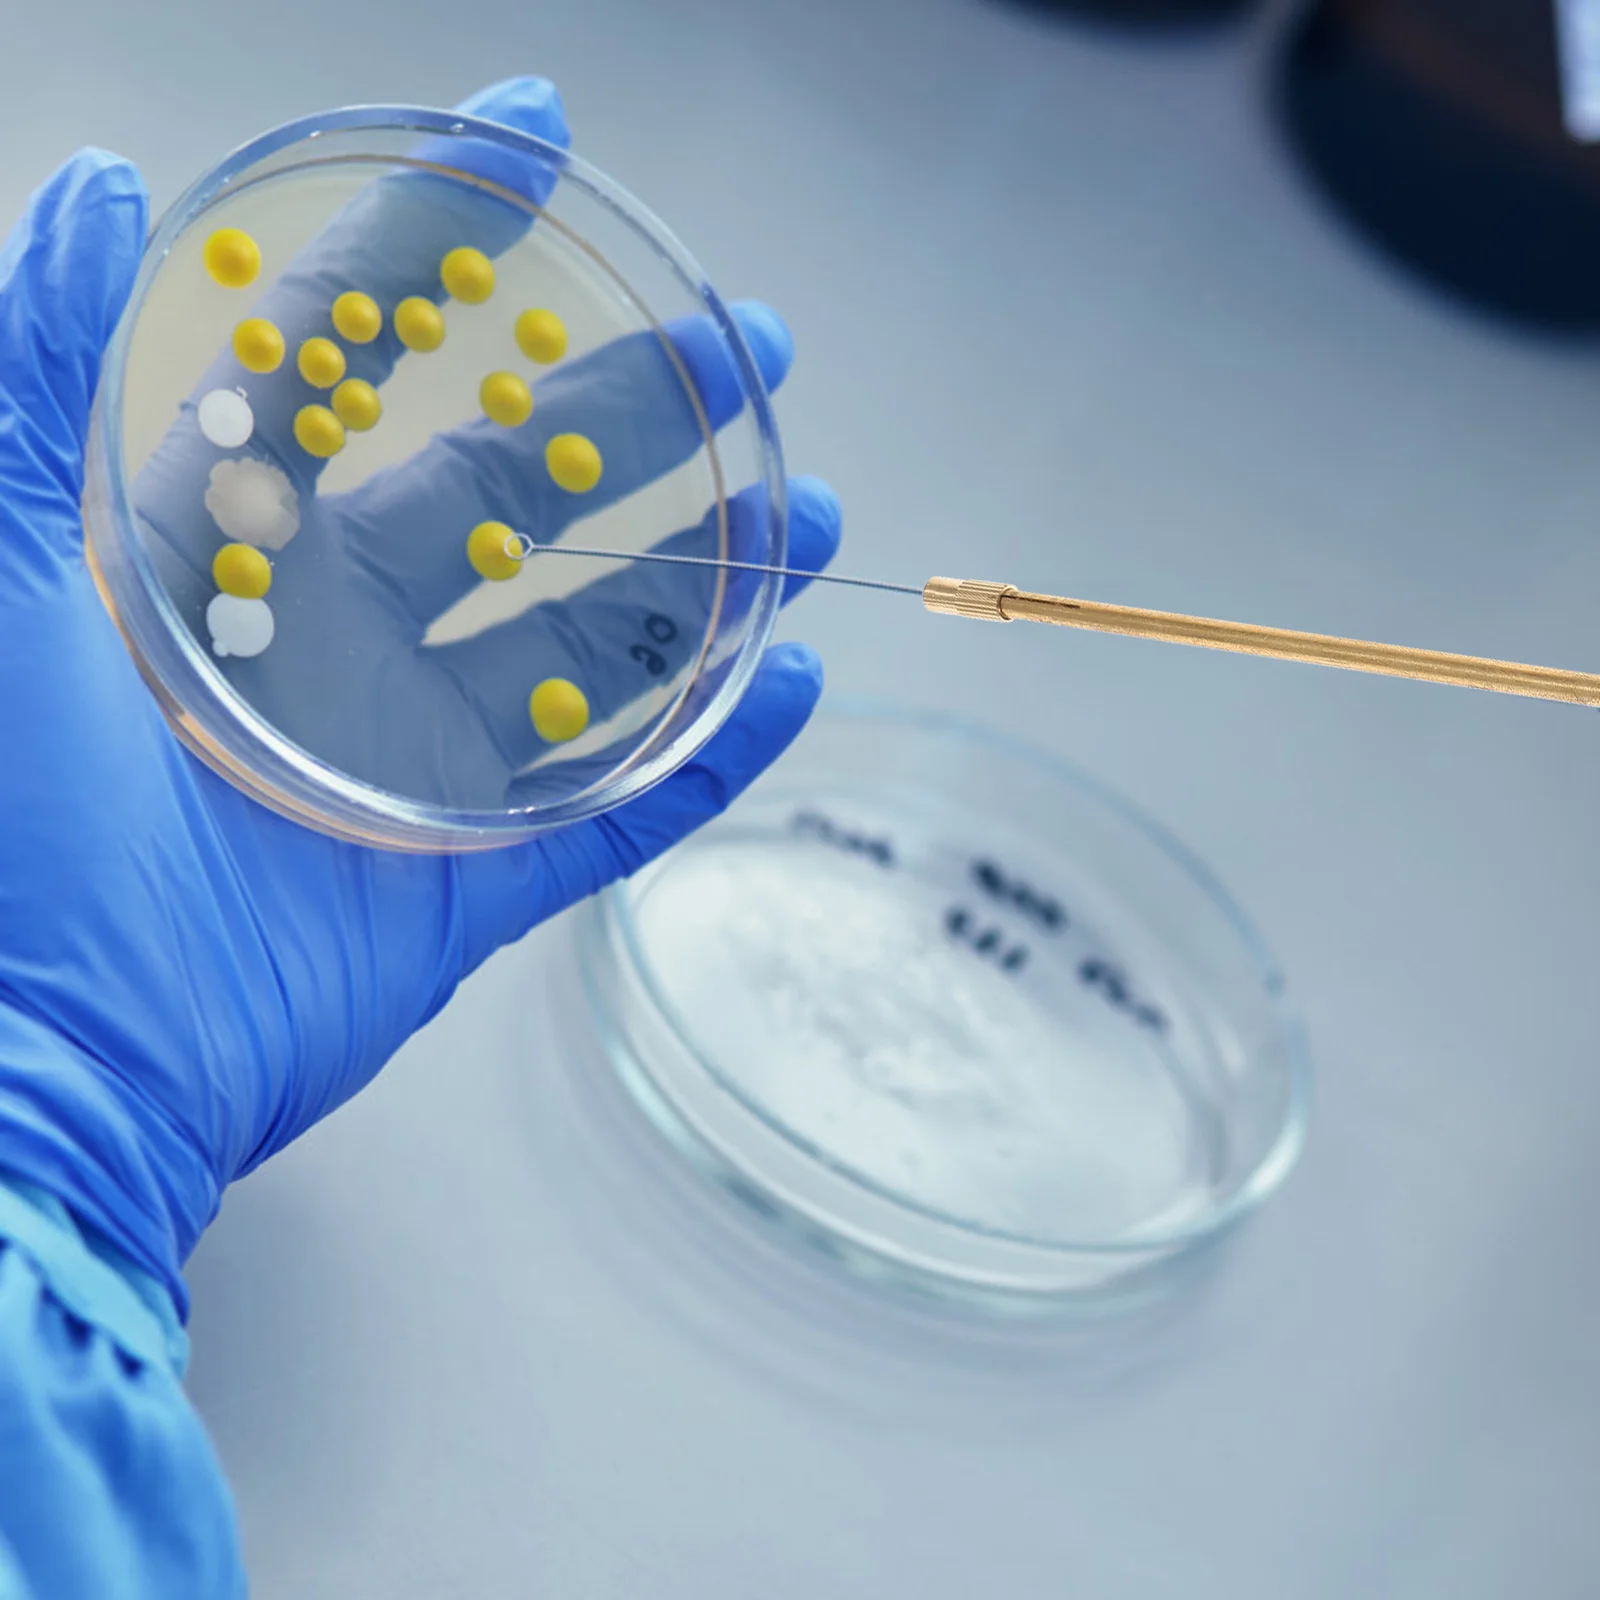

Гладкая тянущаяся папка на молнии, прочная и износостойкая мягкая и прочная сумка для хранения мелочей, Офисная Сетчатая Сумка для файлов
Price history chart & currency exchange rate
Customers also viewed

$11.82
Angle Grinder To Grooving Machine For M14 Universal Head Electric Head Adapter Cut Thinnest Mortar Gypsum Wall Multi-tool Blade
aliexpress.com
$56.35
Coats Women Clothing Korean Fashion Trending Products Chaquetas Invierno 2022 M Cardigans Vetement Femme Cardigan Kpop
aliexpress.com
$26.66
For Sipeed Maix Bit RISC-V Dual Core 64Bit AI+LOT K210 Development Board 8M Byte SRAM QVGA@60Fps/VGA@30Fps Inline Panel
aliexpress.com
$49.33
Autumn and winter coral fleece pajamas girl lovely cardigan autumn flannel big children's home wear 2022 new two-piece set
aliexpress.com
$0.78
25 Strips/Set Ketone Test Strips Urine Tester Test Protein Urine Test Strips Urinary Tract Infection Check Test Strips
aliexpress.com
$17.11
Latest version Xentry v2023.03 remote install vediamo wis/epc for MB Star C4 C5 C6 tool For mb car and truck diagnostic software
aliexpress.com
$131.61
36V Front iMortor wheel Electric Bike Conversion Kit with 20" 24" 26" 700C 29" Motor Wheel eBike Electric Bicycle Conversion Kit
aliexpress.com
$137.09
pass diamond tester luxury jewelry 925 sterling silver gold plated tennis necklace bracelet 8mm moissanite tennis chain
dhgate.com
$55.21
2023 skel-casual shoes skel low genuine leather sneaker designer mens spring shoe leather bones skeleton applique upper low-cut runner men w
dhgate.com
$21.03
men casual shorts summer male fashion solid color short pants bottoms jogging cotton sweatpant trousers gym workout trousers4216433, White;black
dhgate.com
$5.93
2023New HSABAT 4900mAh HB486486ECW Battery for Huawei P30Pro P30 Pro for Huawei Mate20 Pro Mate 20 Pro
aliexpress.com
$12.37
Folding Trolley Cart for Luggage Lightweight Aluminum Collapsible Portable Fold Dolly for Travel Shopping
aliexpress.com
$30.57
WUHE Plaid Sequined Long Sleeve Stand Collar Bodycon Midi Women Dress 2023 Spring New Evening Sexy Party Club Dresses Vestidos
aliexpress.com
$3.73
Beadsteeth Repair Fitting Temporary Kit Fillingthermal Veneers Adhesivereplacement False Fake Bead Broken Dentistveneer Missing
aliexpress.com
$3.40
Inoculation Microbiologyparts Rod Petri Reusable Laboratoryinoculating Agar Dish Ear Billeau Dishes Lidsglass Accessory Supplies
aliexpress.com
$7.98
Blue Xmas Tree Snow Table Cloth with Dust-Proof Wrinkle Resistant Waterproof Decorative Table Cover
aliexpress.com
$4.21
Line Wall Art Stickers for Home Wall Decor Literary Lines For Men And Women Bedroom Entrance Commercial Wallpapers Decoration
aliexpress.com
$76.44
casual shoes designer low cut sneakers leisure lace up black white blue ndsgef with spikes platform sneakers for men womem loafers rmbvnrsdf
dhgate.com
$85.84
luxurys designers briefcase bag ladies brand men handbag fashion handbags shoulder bucket bags cossbody totes clutch waterproof wallet artwo
dhgate.com
$26.09
22ss designers tee mens womens t shirts camouflage pattern man paris fashion t-shirt short sleeve luxurys tshirts blue white m-3xl, White;black
dhgate.com
$75.59
og jorden 4 4s basketball shoes men women jumpman jordam 4 red thunder infrared black cat bred university blue shimmer royalty mens tra267f
dhgate.com
$330.00
Tenveo audio conference speaker cascade studio condenser microfono usb Portable speakerphone
aliexpress.com
$69.00
CDAXILAN new arrivals sandals women patent leather middle square heel buckle strap girls ladies party wedding shoes red beige
aliexpress.com
$9.18
Ceramic Tile Glass Cutting One-Piece Cutter Portable Multifunctional Tool 2-In-1 Multifunctional Hand Tool
aliexpress.com
$14.38
Princess Dress Kids Fashion Sequin Star Tutu Dresses Children Clothing Baby Girl Clothes Short Sleeve Tulle Dress Vestidos D1137
aliexpress.com